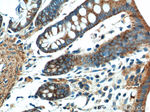
FSTL1 Antibody in Immunohistochemistry (Paraffin) (IHC (P))

Search
Proteintech
FSTL1 Polyclonal Antibody
{{$productOrderCtrl.translations['antibody.pdp.commerceCard.promotion.promotions']}}
{{$productOrderCtrl.translations['antibody.pdp.commerceCard.promotion.viewpromo']}}
{{$productOrderCtrl.translations['antibody.pdp.commerceCard.promotion.promocode']}}: {{promo.promoCode}} {{promo.promoTitle}} {{promo.promoDescription}}. {{$productOrderCtrl.translations['antibody.pdp.commerceCard.promotion.learnmore']}}
产品信息
20182-1-AP
种属反应
已发表种属
宿主/亚型
分类
类型
抗原
偶联物
形式
浓度
规格
纯化类型
保存液
内含物
保存条件
运输条件
产品详细信息
Immunogen sequence: MWKRWLALA LALVAVAWVR AEEELRSKSK ICANVFCGAG RECAVTEKGE PTCLCIEQCK PHKRPVCGSN GKTYLNHCEL HRDACLTGSK IQVDYDGHCK EKKSVSPSAS PVVCYQSNRD ELRRRIIQWL EAEIIPDGWF SKGSNYSEIL DKYFKNFDNG DSRLDSSEFL KFVEQNETAI NITTYPDQEN NKLLRGLCVD ALIELSDENA DWKLSFQEFL KCLNPSFNPP EKKCALEDET YADGAETEVD CNRCVCACGN WVCTAMTCDG KNQKGAQTQT EEEMTRYVQE LQKHQETAEK TKRVSTKEI (1-308 aa encoded by BC000055 )
靶标信息
Follistatin-like protein 1 (FSTL1) is a widely-expressed, extracellular glycoprotein that is homologously grouped into the osteonectin (BM-40/SPARC) family of secreted proteins based on its possession of both a follistatin-like and extracellular calcium-binding domain. Initially identified as a TGF-beta-inducible protein in a cloned mouse osteoblast cell line, FSTL1 has since been implicated in an array of cell-type-specific functions, such as the regulation of proliferation, differentiation, apoptosis and migration, as well as a number of biological processes, including embryonic development, inflammatory response, angiogenesis, tumorigenesis, and immune disease pathogenesis. Highly conserved across mammalian species and widely expressed in human tissues, FSTL1 can be upregulated through signaling mediators of the innate immune system,such as TLR4 agonists and the arthritogenic cytokine IL-1beta via NFkappaB pathways, to stimulate the expression and secretion of pro-inflammatory cytokines, including TNF-alpha, IL-1beta, IL-6 and IL-8. While cells of mesenchymal lineage are capable of FSTL1 production, FSTL1 expression is notably absent from cells of hematopoietic lineage under normal physiological conditions. Macrophages and monocytes are, however, capable of taking up FSTL1 at sites of inflammation where FSTL1 stimulation can cause the expression of caspase-1 and its resultant enzymatic cleavage of active IL-1beta from pro-IL-1beta. Whereas the overexpression of FSTL1 has been noted as a substantial contributor to the progression of immune diseases like rheumatoid arthritis (RA) and osteoarthritis (OA), diminished FSTL1 serum levels have been identified as playing a significant part in both ovarian and endometrial carcinogenesis, where it directly affects cell proliferation, migration and invasion.
仅用于科研。不用于诊断过程。未经明确授权不得转售。
生物信息学
蛋白别名: FLJ50214; FLJ52277; Follistatin-like protein 1; Follistatin-related protein 1; unnamed protein product
基因别名: FRP; FSL1; Fstl; FSTL1; MIR198; OCC-1; OCC1; tsc36
UniProt ID: (Human) Q12841, (Rat) Q62632
Entrez Gene ID: (Human) 11167, (Rat) 79210